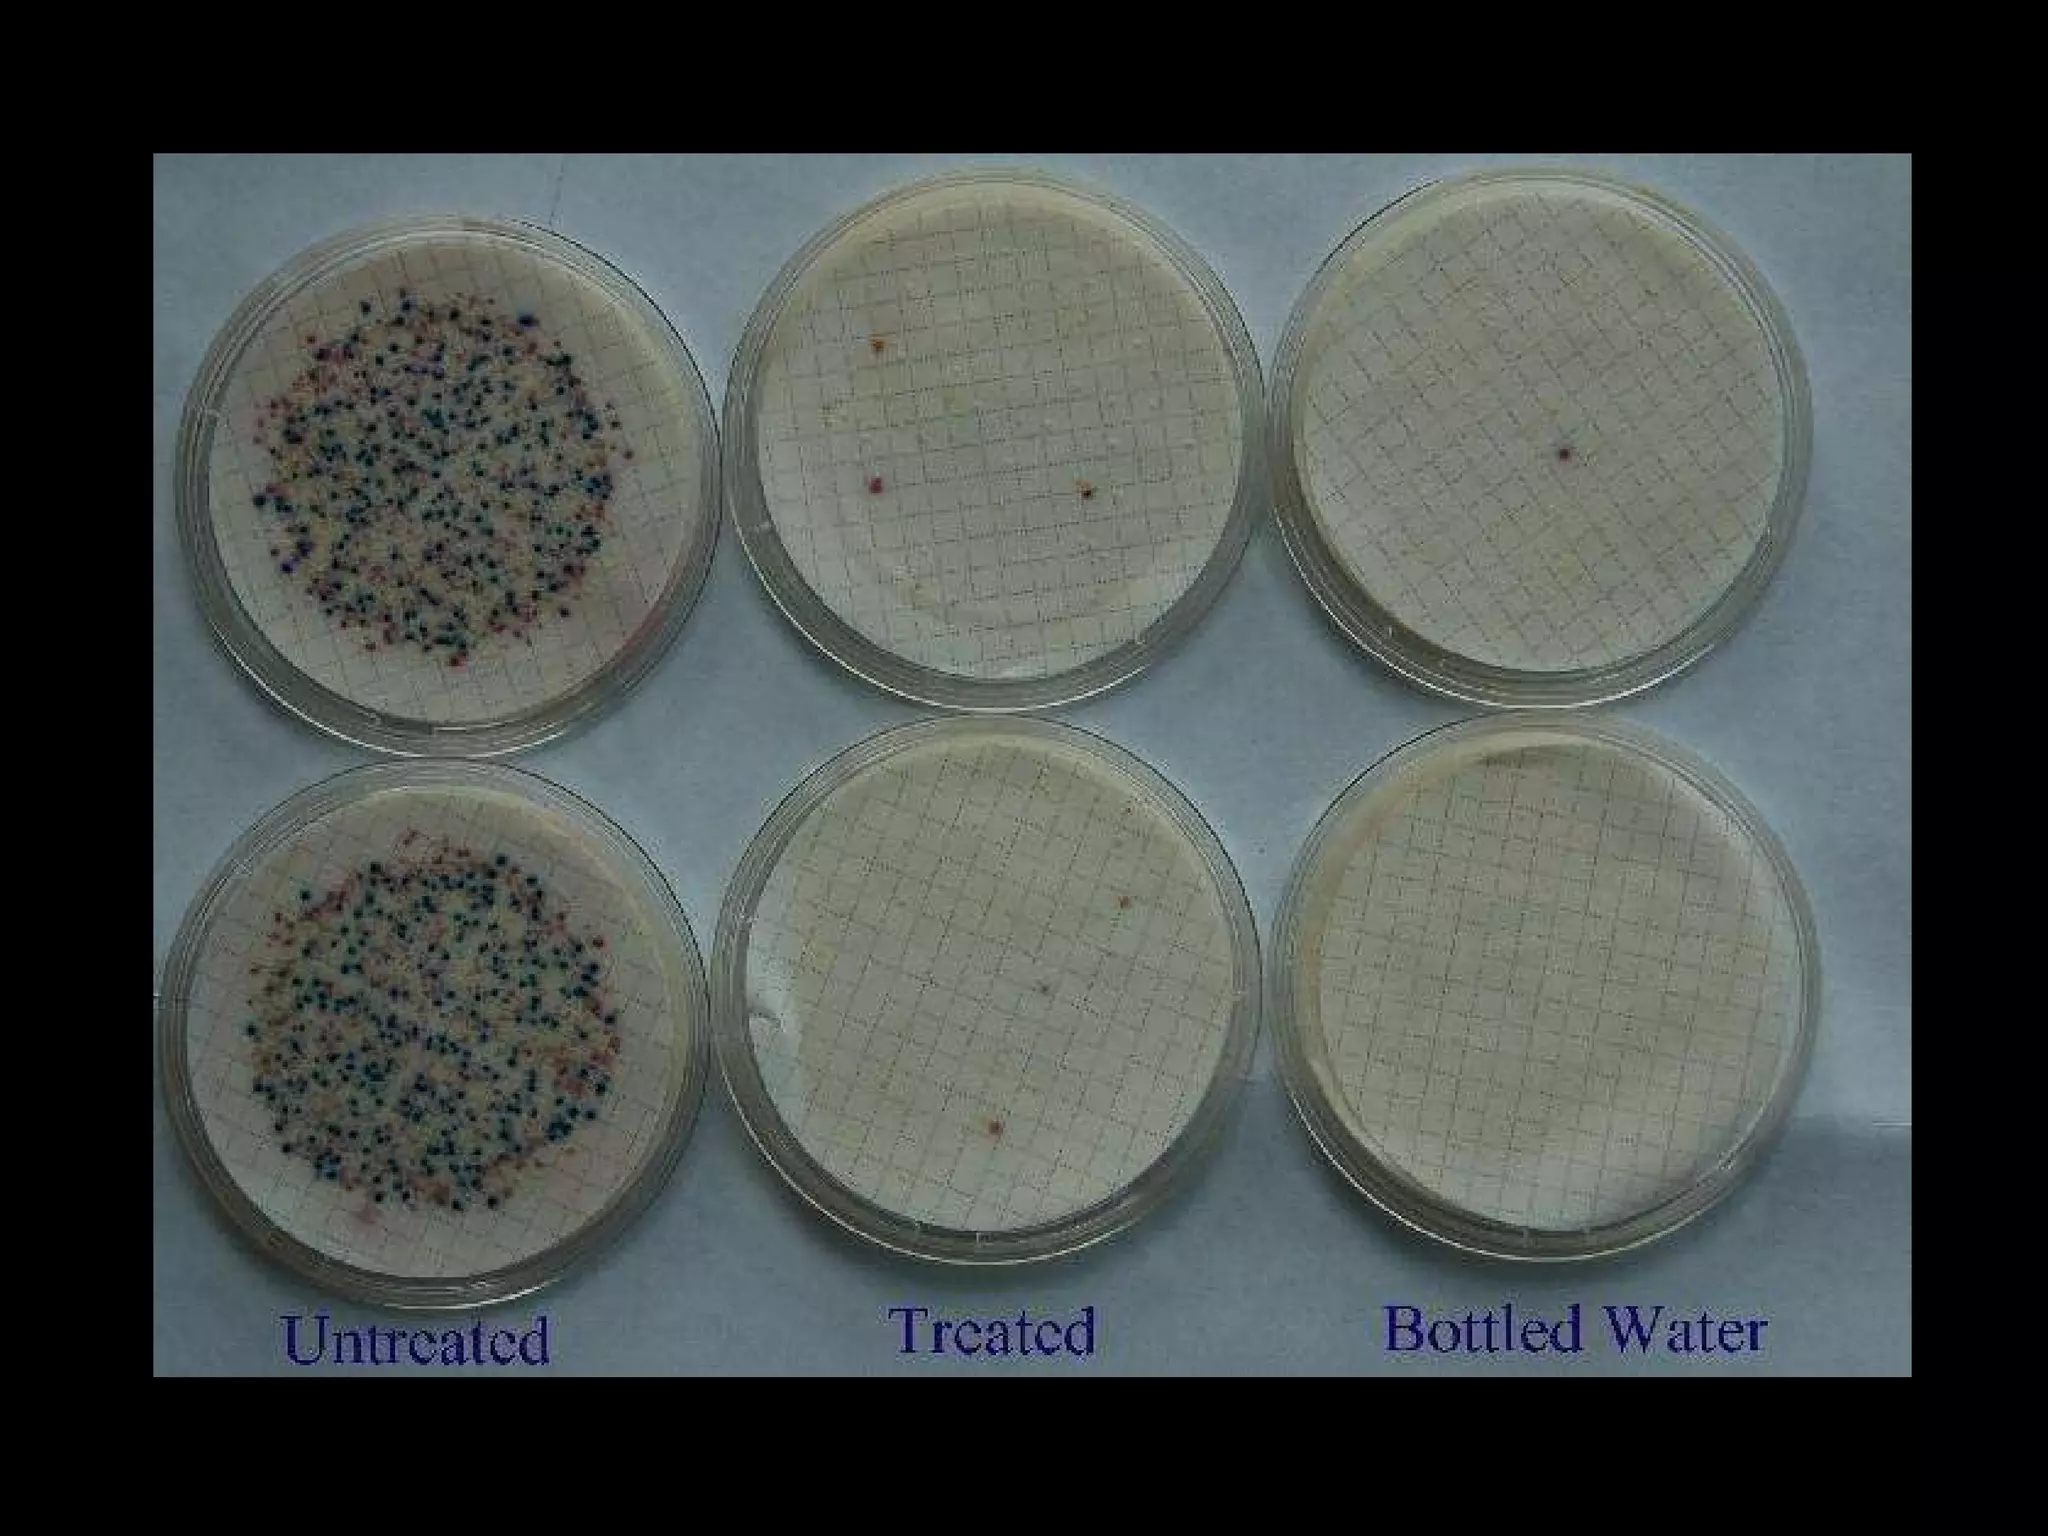

Engineers Without Borders is a nonprofit organization founded in 2000 with 291 chapters and over 12,000 members worldwide. The document discusses several of EWB's projects providing biodiesel in Jamaica, building a dormitory in Thailand, and developing a water treatment system in Mae Nam Khun capable of treating 55,000 liters per day through partnerships with local universities, businesses, and international organizations. It emphasizes the importance of clean water, noting 1.5 million deaths annually from waterborne illness.

![Department of Civil & Environmental Engineering Phillip Thompson [email_address] Building Partnerships](https://image.slidesharecdn.com/oct22010afinal-101016000255-phpapp01/75/Engineers-Without-Borders-presentation-2-2048.jpg)



















![“ Every day more children die from dirty water than HIV/AIDS, malaria, war and accidents all put together…Water is the most important environmental and human-rights issue of them all. [The worst effects of climate change will be felt decades from now.] The world is running out of fresh water today.” - Maude Barlow National Chair Council of Canadians](https://image.slidesharecdn.com/oct22010afinal-101016000255-phpapp01/75/Engineers-Without-Borders-presentation-22-2048.jpg)

![Department of Civil & Environmental Engineering Phillip Thompson [email_address] Building Partnerships](https://image.slidesharecdn.com/oct22010afinal-101016000255-phpapp01/75/Engineers-Without-Borders-presentation-36-2048.jpg)

